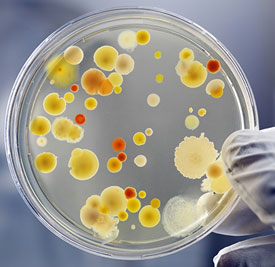

Примерно у 80% населения стафилококк живет на слизистых оболочках. Какое-то время условно-патогенные микробы не причиняют никакого вреда организму. Однако любое снижение иммунитета может дать толчок к интенсивному размножению бактерий, и вот тогда стафилококки становятся причиной множества опасных заболеваний. Золотистый стафилококк наиболее опасный из всей группы этих болезнетворных микроорганизмов. Он провоцирует большинство ЛОР-болезней, кишечных инфекций, кожных недугов. Избавиться от заболевания, спровоцированного стафилококком, бывает весьма непросто.
Причины заражения золотистым стафилококком
Золотистый стафилококк — очень живучая бактерия. Он устойчив к замораживанию и высушиванию, сложно поддается влиянию ультрафиолетовых лучей и химикатов. В пыли микроорганизм способен прожить около 100 дней, а в высушенном виде — больше полугода.
Золотистый стафилококк является достаточно устойчивой бактерией
Бактерии выживают и в соленой воде, им не страшна перекись водорода, а температурный режим в 70 градусов они выдерживают более часа. Убивает стафилококк кипячение и раствор фенола, и то после часового воздействия на него.
Если человек не является носителем инфекции, заразиться ею вполне реально в обычной больнице. Стафилококки первые в списке бактерии, по данным исследованиям ВОЗ, которыми чаще всего заражаются в медицинских учреждениях.
Микроорганизмы передаются контактным и воздушно-капельным путем.
Занести в организм инфекцию возможно через:
- рукопожатия, дверные ручки, предметы личной гигиены;
- незащищенный сексуальный контакт;
- употребление немытых или несвежих продуктов;
- кровь во время беременности от матери к малышу;
- открытые раны или ожоги;
- медицинские инструменты, перевязочный материал;
- трещины на сосках во время грудного вскармливания.
В группе риска находятся инъекционные наркоманы, лица, которые наносят татуировку или делают пирсинг в сомнительном заведении. Беременные, новорожденные, пожилые люди, больные с пониженным иммунитетом или иммунодефицитом более склонны к заражению, поскольку защитная функция их организма наиболее уязвима к инфекциям.
Стафилококк может легко проникнуть в организм человека, который перенес тяжелое респираторную инфекцию, грипп, дисбактериоз. Рискуют заболеть и пациенты после хирургического вмешательства или длительной терапии антибиотиками, люди с нарушенной деятельностью кишечника.
Главная причина инфицирования — сниженный иммунитет человека.
Как распознать клинические проявления болезни?
Признаки инфекции в горле
Определить симптомы золотистого стафилококка у взрослых не просто. Патогенная бактерия способствует развитию многих заболеваний в горле: ларингита, фарингита, тонзиллита.
Заболевание напоминает гнойную ангину
А чаще всего признаки инфекции схожи симптомами гнойной бактериальной ангины:
- увеличение миндалин
- утрата аппетита
- резкое повышение температуры тела до 39-40
- припухлость лимфатических узлов
- сильная боль при глотании слюны
- сонливость, общая мышечная слабость
- покраснение и отек горла
- образование гнойничков и налета на слизистой оболочке
- нестерпимая головная боль
Поскольку эти симптомы характерны и для других заболеваний горла, для точной диагностики необходимо провести бактериологический посев (мазок) ротовой полости. Неправильное лечение стафилококковой инфекции способствует перерождению болезни в хроническую форму, что может привести к пневмонии.
Люди, страдающие от частых ангин, обострения хронического тонзиллита, обязательно должны пройти проверку на наличие золотистого стафилококка в горле.
Инфекция способна проникать вглубь организма и может дать осложнение на сердце, почки, костную систему.
Без микробиологического исследования определить возбудителя инфекции судя только по внешним симптомам невозможно.
Симптомы стафилококка в носу
Полость носа — одно из любимых мест обитания золотистого стафилококка. Его появлению способствует не только снижение общего иммунитета, но и местного.
Стафилококк размножается при определенных условиях
В результате переохлаждения, чрезмерного использования антибактериальных капель в нос, сосудосуживающих средств или при наличии сопутствующего вируса стафилококк начинает активно размножаться.
Общие симптомы инфекции такие же, как и при заболеваниях носоглотки: общая слабость, признаки интоксикации, покраснение кожи носа и возникновение гнойных образований.
Патогенная бактерия способна вызвать гайморит, по мере распространения инфекции, у больного отекают веки, появляется заложенность носа, боль в лице, отдающая в верхнюю челюсть или лоб.
Часто из-за бурного роста количества стафилококка развивается фронтит. Он характерен болевым синдромом в области лба, особенно над бровями. Выделения из носа увеличиваются по утрам, возможно головокружение.
При хроническом рините стафилококкового происхождения слизь из носа приобретает неприятный запах и зеленоватый оттенок.
Одними из наиболее частых признаков стафилококка является насморк с густой и вязкой слизью, зуд в носу, появление небольших гнойных прыщей внутри носовых ходов или под носом.
Стафилококк и кожные болезни
Основной симптом кожного стафилококка — сыпь разного рода. Чаще всего инфекция проникает вглубь кожных покровов, образовывая гнойные прыщи. В большинстве случаев бактерии поражают волосяные луковицы, потовые и сальные железы.
Золотистый стафилококк вызывает заболевания кожи
Золотистый стафилококк часто становится причиной множества болезней кожи:
- пиодермия (фурункул, карбункул, фолликулит, сикоз, гидраденит, остиофолликулит)
- рожистое воспаление
- флегмона, импетиго
- панацирий (воспаление околоногтевого валика)
- множественные абсцессы у детей (синдром ошпаренных младенцев)
Кожа на месте распространения инфекции всегда красная, отечная, прикосновение приносит боль. При фурункулезе возникают крупные прыщи из которых сочиться гной, при рожистом воспалении сыпь незначительная, но температура тела может достигать 40, возможна тошнота или рвота.
Стафилококковая пиодермия характеризуется мелкими зудящими высыпаниями, которые после расчесывания распространяются на большие фрагменты кожи.
Размер высыпаний: от мелкой булавочной головки до небольшой детской ладошки (карбункул).
Помимо сыпи и повышенной температуры, иногда возникают признаки интоксикации в виде озноба и слабости тела, шелушение кожи, отслойка верхнего слоя кожи.
Кишечные заболевания
Поскольку стафилококк отлично адаптируется в окружающей среде, он зачастую размножается в продуктах питания с пройденным сроком годности. Любит бактерия селиться в жаркое время года в тортах, салатах с майонезом, пирожных с кремом. Очень часто золотистый стафилококк обнаруживают в рыбе, яйцах, молочных продуктах, мясе.
Первый симптом заражения инфекцией — ярко выраженные признаки кишечного отравления:
- тошнота и рвота
- диарея
- резкие режущие приступы боли в кишечнике, внизу живота
- спазмы, кишечные колики
Стул становится водянистый, постепенно вероятно появление в кале слизи или кровянистых примесей. Позывы в туалет могут достигать до 10 раз в сутки.
В результате временного обезвоживания у человека появляется слабость мышц, небольшой подъем температуры до субфебрильных показателей (37-37,5).
Если иммунитет больного очень слаб, то в таком случае существует риск развития инфекционно-токсического шока. Артериальное давление при этом падает значительно ниже нормы, человек может потерять сознание и впасть в кому.
Скрытый период отравления продуктами, зараженными золотистым стафилококком, длится недолго, симптомы проявляются уже в течение 2-4 часов после употребления их в пищу.
О симптомах золотистого стафилококка узнайте из предложенного видеоматериала.
Как лечить стафилококковую инфекцию?
Антибиотикотерапия
Избавиться от присутствия золотистого стафилококка в крови невозможно, а вот победить стафилококковую инфекцию вполне реально, хотя и сложно. Не все болезни, причиненные микроорганизмами, нуждаются в приеме антибиотиков.
К тому же, стафилококк устойчив к большинству известных антибиотиков, в том числе и к пенициллину. Зато бактерия крайне чувствительна к анилиновым красителям (обычной зеленке, которая есть в каждом доме).
Кишечная инфекция не всегда лечится антибиотиками
Кишечная инфекция, спровоцированная стафилококком, антибиотиками не лечится, отравление проходит самостоятельно. При заболеваниях носоглотки и кожи в большинстве случаев назначаются антибиотики:
- Цефуроксим, Цефалексин, Цефазолин
- Ванкомицин, Амоксиклав, Аугментин
- Флемоксин, Далацин, Тетрациклин
Кроме антибиотиков во время лечения стафилококковой инфекции пропить иммуностимулирующие препараты для восстановления защитной функции организма (Бронхомунал, Респиброн, Рибомунил), иммуноглобулины (Имудон).
Для местного применения используются:
- для носоглотки — обработка слизистых оболочек масляным или спиртовым раствором хлорофиллипта, ИРС-19;
- для кожи — мазь для наружного применения с мупироцином (Бактробан), Супироцин, Бондерм.
В арсенале врачей много вариантов для лечения стафилококковой инфекции, каждый случай должен рассматриваться индивидуально.
Народные методы
Снизить рост болезнетворных микроорганизмов ни одно народное средство не в силах, однако, некоторые рецепты помогают снять болезненные ощущения. Целители рекомендуют ввести в рацион абрикосовое пюре, его действие приравнивается к природному антибиотику. В день необходимо съедать не меньше 500 гр этого фрукта. Теми же свойствами обладает и черная смородина.
Для орошения носоглотки применяют народные средства
Для орошения носоглотки при стафилококке используются отвары лекарственных растений: ромашки, шалфея, корня лопуха, мать-и-мачехи, цветков календулы, подорожника.
Все травы обладают натуральным противовоспалительным и антисептическим свойством. Приготовить отвар просто: залить кипятком столовую ложку сухой травы, дать час настояться и промывать нос и горло не меньше 3-х раз в день.
Чтобы организм смог дать отпор болезни, народная медицина применяет настойки эхинацеи, женьшеня, отлично восстанавливает иммунитет отвар шиповника. Для горла рекомендуется сбор из душицы, барбариса, корня солодки и эвкалипта. Травы настаиваются полтора часа, для лучшего эффекта можно добавить немного меда.
Во избежание ожога слизистых оболочек кожи любой народный способ (дозировку трав, продолжительность приема) следует согласовать со специалистом.
Альтернативный способ: бактериофаги
Исходя из того, что золотистые стафилококк все больше адаптируется к современным антибиотикам, в последние годы популярность приобретают стафилококковые бактериофаги. Препарат действует на бактерию, проникая внутрь нее и разрушая изнутри. Бактериофаг убивает конкретный патогенный микроорганизм, в отличие от антибиотика широкого спектра, который разрушает и вредные и полезные бактерии.
Для назначения бактериофага нужно точная диагностика
Для того чтобы назначить такой препарат, врач должен точно диагностировать возбудителя болезни. Бактериофаги используются при лечении стафилококковой пневмонии, фурункулезе, остеомиелите, фарингите.
Курс лечения варьируется от 5 до 14 дней в зависимости от тяжести болезни. Производят медикамент в форме таблеток, свечей, аэрозолей и в жидкости для инъекций. Их применение оправдано для лечения беременных, кормящих мам, ведь бактериофаги не наносят вреда полезным микроорганизмам.
Побочные эффекты наблюдались редко, но пациенты все равно боятся его использовать. Бактериофаг относится к вирусам, его сложно отнести к какому-либо виду фармакологии. Однако этот препарат считается весьма эффективным в лечении золотистого стафилококка, и врачи часто применяют его на практике.
Обычно во время употребления бактериофагов не наблюдалось аллергической реакции, главное — соблюдать врачебные инструкции.
Как лечить инфекцию при беременности?
Беременные женщины находятся в группе риска
Беременные женщины первыми попадают в группу риска по инфицированию золотистым стафилококком. Их иммунитет существенно снижен и чувствителен к внешнему воздействию. Паниковать по поводу обнаружения бактерии в мазке не стоит. Если показатель стафилококка не превышает нормальные показатели, то никаких лекарств беременной принимать не нужно.
А вот стафилококковая инфекция чрезвычайно опасна и для мамы, и для ребенка. В результате заражения существует высокий риск пороков развития, а в тяжелых случаях самопроизвольный аборт.
Самолечение в данной ситуации запрещено. Гинеколог должен назначить женщине препараты, учитывая особенности ее беременности, наличие сопутствующих заболеваний. Острое течение болезни снимают антибиотиками щадящего действия, бактериофагами, иммуностимулирующими средствами.
Из местных средств применяют раствор Хлорофиллипта на масляной основе не меньше чем две недели. Во время лечения нельзя принимать ванну, греть зараженные участки тела. Под воздействием тепла бактерии размножаются еще быстрее и распространяются дальше по организму.
Для безопасности ребенка о существовании золотистого стафилококка в организме лучше узнать на этапе планирования беременности, предварительно сдав анализы.
С золотистым стафилококком люди с сильным иммунитетом живут годами, даже не догадываясь о его существовании. Поэтому так важно заботиться о своем самочувствии. Помимо стандартных правил здорового образа жизни, важно следить за гигиеной рук, тщательней выбирать продукты, проверять их срок годности. Необходимо мыть руки после посещения больницы, общественного транспорта, супермаркета. Большую часть бактерий, микробов и вирусов мы приносим домой на своих руках, на слизистых носа и горла. Все эти нехитрые правила помогут как можно реже болеть опасными заболеваниями, вызванными золотистым стафилококком.
Заметили ошибку? Выделите ее и нажмите Ctrl+Enter, чтобы сообщить нам.

Стафилококк принадлежит группе положительных, неподвижных, анаэробных, условно-патогенных для организма человека микроорганизмов. Тип метаболизма – окислительный и ферментативный. Споры и капсулы не образуют. Диаметр клетки стафилококка составляет 0,6-1,2 мкм, в зависимости от штамма (вида). Наиболее распространенные цвета – фиолетовый, золотистый, желтый, белый. Некоторые стафилококки способны синтезировать характерные пигменты.
Большинство видов бактерии стафилококк окрашены в фиолетовый цвет и распространяются гроздями, схожими на виноградные, в связи с чем они и получили свое название, которое в переводе с древнегреческого языка означает «σταφυλή» (виноград) и «κόκκος» (зерно).
Стафилококки в определенном количестве практически всегда находятся на поверхности тела человека (в носо- и ротоглотке, на коже), но при попадании данной инфекции внутрь, она ослабляет организм, а некоторые из видов стафилококка даже способны вызвать развитие различных заболеваний, причем почти всех органов и систем, особенно если иммунная система ослаблена. Дело в том, что стафилококк, попадая внутрь, вырабатывает большое количество эндо- и экзотоксинов (яды), которые отравляют клетки организма, нарушая их нормальную жизнедеятельность. Наиболее распространенные патологии, которые вызывают стафилококки – пневмония, токсический шок, сепсис, гнойные поражения кожи, нарушения в работе нервной, пищеварительной и других систем, общее отравление организма. Не редким случаем является присоединение стафилококковой инфекции, в качестве вторичного заболевания, как осложнение при других болезнях.
Условная патогенность данного вида инфекции говорит о том, что негативным образом на здоровье человека, или животного, стафилококки действуют только при определенных условиях.
Замечено, что больше всего, заражению стафилококком подвержены дети, что связано с несформировавшейся до конца иммунной системы и несоблюдением правил личной гигиены, а также люди преклонного возраста.
Причины стафилококка

Как передается стафилококк? Рассмотрим наиболее популярные пути заражения стафилококковой инфекцией.
Как стафилококк может попасть в организм?
Воздушно-капельный путь. В сезон респираторных заболеваний, частое пребывание в местах большого скопления людей также повышает риск заражения, причем не только стафилококковой, но и многими другими видами инфекции, в т.ч. вирусной, грибковой. Чиханье, кашель – подобные симптомы служат своего рода маячками, от которых здоровым людям, по возможности, нужно держаться подальше.
Воздушно-пылевой путь. Домашняя и уличная пыль содержит в себе большое количество различных микроскопических частичек – пыльцы растений, слущенных частичек кожи, шерсть различных животных, пылевых клещей, частички различных материалов (ткань, бумага), и все это обычно приправлено различной инфекцией – вирусами, бактериями, грибками. Стафилококк, стрептококк и другие виды инфекции очень часто находятся в пыли, и когда мы дышим подобным воздухом, это не лучшим образом сказывается на нашем здоровье.
Контактно-бытовой путь. Обычно заражение происходит при совместном использовании предметов личной гигиены, постельного белья, особенно если один из членов семьи приболел. Риск заражения повышается при травмировании кожных покровов, слизистой оболочки.
Фекально-оральный (алиментарный) путь. Инфицирование происходит при употреблении пищи грязными руками, т.е. — при несоблюдении правил личной гигиены. Тут стоит также отметить, что заражение алиментарным путем также является частой причиной заболевания таким болезнями, как — ботулизм, гепатит и другими сложными инфекционными болезнями.
Медицинский путь. Заражение стафилококком происходит при контакте недостаточно чистыми медицинскими инструментами, как при хирургических вмешательствах, так и при некоторых видах диагностики, которые подразумевают под собой нарушение целостности кожного покрова или слизистых оболочек. Это обычно обусловлено обработкой инструментов средством, к которому стафилококк выработал стойкость.
Как стафилококк может серьезно навредить здоровью человека, или что ослабляет иммунную систему?
Наличие хронических болезней. Большинство болезней свидетельствуют об ослабленной иммунной системе. Если патологические процессы уже происходят в организме, ему сложнее защищаться от других болезней. Поэтому, любое заболевание повышает риск присоединения к нему вторичной инфекции, и стафилококковая одна из них.
Наиболее распространенными заболеваниями и патологическими состояниями, при которых стафилококк часто атакует больного, являются: переохлаждение организма, ОРЗ, ОРВИ, грипп, ангина, фарингит, ларингит, трахеит, бронхит, пневмония, сахарный диабет, ВИЧ-инфекция, туберкулез, заболевания эндокринной и других систем, а также другие хронические болезни.
Кроме того, риск заражения стафилококком повышают:
- Вредные привычки: курение, употребление алкогольных напитков, употребление наркотических средств;
- Стрессы, отсутствие здорового сна;
- Малоподвижный образ жизни;
- Употребление малополезной и вредной пищи;
- Гиповитаминозы (недостаточность витаминов);
- Злоупотребление некоторыми лекарственными препаратами – сосудосуживающие средства (нарушают целостность слизистой носа), антибиотики;
- Нарушения целостности кожных покровов, слизистых оболочек полости носа и рта.
- Недостаточное проветривание помещений, в которых человек часто пребывает (работа, дом);
- Работа на предприятиях с большой загрязненностью воздуха, особенно без защитных средств (маски).
Симптомы стафилококка
Клиническая картина (симптомы) стафилококка могут быть весьма разнообразными, что зависит от поражаемого органа, штамма бактерии, возраста человека, функциональности (здоровья) иммунитета потенциального больного.
Общими симптомами стафилококка могут быть:
- Повышенная и высокая температура тела (часто локальная) – до 37,5-39 °С, озноб;
- Гиперемия (прилив крови к месту воспалительных процессов);
- Общее недомогание, слабость, болезненность;
- Отечность;
- Пиодермия (развивается при попадании стафилококка под кожу), фолликулит, карбункулез, фурункулез, акне, экзема;
- Снижение аппетита, боль в животе, тошнота, рвота, понос;
- Синуситы – ринит (насморк), гайморит, фронтит, этмоидит и сфеноидит;
- Болезни дыхательных путей: ангина, фарингит, ларингит, трахеит, бронхит и пневмония;
- Гнойные выделения из носоглотки и ротоглотки желто-зеленого цвета;
- Нарушение чувства обоняния;
- Затрудненное дыхание, одышка, кашель, чиханье;
- Изменение тембра голоса;
- Бессонница;
- Головные боли;
- Остеомиелит;
- Холецистит;
- Синдром токсического шока;
- Падение артериального давления;
- «Синдром ошпаренных младенцев»;
- Нарушения функционирования некоторых органов и тканей, которые стали очагом оседания инфекции;
- Ячмень на веке.
Осложнения стафилококка:
- Абсцесс легких;
- Эмпиема плевры;
- Менингит;
- Пиелонефрит;
- Потеря голоса;
- Лихорадка;
- Эндокардит;
- Судороги;
- Флегмоны;
- Перитонит;
- Сепсис.
Виды стафилококка
1. Золотистые стафилококки (Staphylococcus aureus) — S. aureus, S. Simiae.
Золотистые стафилококки являются наиболее патогенными для человеческого организма. Попадая внутрь, они способны вызвать воспалительные процессы и поражения практически всех органов и тканей человека, а также образовывать золотистый пигмент. Золотистый стафилококк обладает свойством вырабатывать фермент коагулазы, из-за чего, его иногда называют — коагулазоположительный стафилококк.
2. Ушные стафилококки (Staphylococcus auricularis) — S. auricularis.
3. Staphylococcus carnosus — S. carnosus, S. condimenti, S. massiliensis, S. piscifermentans, S. simulans.
4. Эпидермальные стафилококки (Staphylococcus epidermidis) — S. capitis, S. caprae, S. epidermidis, S. saccharolyticus.
Эпидермальный стафилококк чаще всего находится на коже и слизистых человека. Является частой причиной таких болезней, как – конъюнктивит, эндокардит, сепсис, гнойные поражения ран кожи и мочевыводящих путей. При нормальном функционировании иммунной системы, организм не дает эпидермальным стафилококкам размножатся внутри организма и поражать его.
5. Гемолитические стафилококки (Staphylococcus haemolyticus) — S. devriesei, S. haemolyticus, S. hominis.
Гемолитический стафилококк является чаще всего причиной таких кожных и мочеполовых заболеваний, как – эндокардит, сепсис, воспалительные с нагноением процессы на коже, цистит и уретрит.
6. Staphylococcus hyicus-intermedius — S. agnetis, S. chromogenes, S. felis, S. delphini, S. hyicus, S. intermedius, S. lutrae, S. microti, S. muscae, S. pseudintermedius, S. rostri, S. schleiferi.
7. Staphylococcus lugdunensis — S. lugdunensis.
8. Сапрофитные стафилококки (Staphylococcus saprophyticus) – S. arlettae, S. cohnii, S. equorum, S. gallinarum, S. kloosii, S. leei, S. nepalensis, S. saprophyticus, S. succinus, S. xylosus.
Сапрофитный стафилококк часто является причиной таких заболеваний мочевыводящих путей, как – цистит и уретрит. Это обусловлено тем, что сапрофитный стафилококк находится преимущественно на кожных покровах гениталий, а также слизистых оболочках мочевыводящих путей.
9. Staphylococcus sciuri – S. fleurettii, S. lentus, S. sciuri, S. stepanovicii, S. vitulinus.
10. Staphylococcus simulans – S. simulans.
11. Staphylococcus warneri – S. pasteuri, S. warneri.
Степени стафилококка
Для определения точной схемы лечения, врачи разделили течение стафилококковой болезни на 4 условных степени. Это связано с тем, что различные виды инфекции, а также их патологическая активность в различное время и при различных условиях различаются. Кроме того, такой подход при диагностике различает стафилококковую инфекцию, к какой группе она принадлежит – полностью патогенное влияние на организм, условно-патогенное и сапрофиты, которые практически не наносят человеку никакого вреда.
Степени стафилококка
Стафилококк 1 степени. Локализация инфекции для забора на диагностику – носо- и ротоглотка, кожный покров, мочеполовая система. Клинические проявления отсутствуют или минимальные. При здоровой иммунной системе, медикаментозная терапия не требуется.
Стафилококк 2 степени. Клинические проявления (симптомы) минимальны или отсутствуют. При наличии жалоб проводится тщательная диагностика на наличие других видов инфекции. Если установлено, что в организме присутствует и другой вид бактерии, в частном порядке назначается антибактериальная терапия.
Стафилококк 3 степени. У пациента присутствуют жалобы. В большинстве случаев необходима антибактериальная терапия, за исключением ситуации, в которой лечащий врач посчитает, что применение антибиотиков неоправданно. Лечение стафилококка 3 степени обычно направлено, прежде всего, на укрепление иммунной системы. Если в течение 2х месяцев, выздоровление силами организма не происходит, разрабатывается индивидуальная схема лечения инфекции, в т.ч. с применением антибактериальных средств.
Стафилококк 4 степени. Терапия направлена на укрепление иммунитета, устранения гиповитаминозов, дисбактериоза кишечника. Перед применением антибактериальной терапии, проводится тщательная диагностика на реакцию конкретного вида стафилококка на препарат.
Диагностика стафилококка
Анализ на стафилококк проводится из мазков, взятых обычно из поверхности кожи, слизистых оболочек верхних дыхательных путей или мочевыделительного канала.
Дополнительными методами обследования могут быть:
Лечение стафилококка

Очень важным является применение антибиотиков на основании диагностики, поскольку определить вид стафилококка по клинической картине практически невозможно, а применение антибиотиков широкого спектра действия может вызвать большое количество побочных эффектов.
Тем не менее, для лечения стафилококка применяются следующие, наиболее популярные антибиотики.
Антибиотики при стафилококке
Важно! Перед применением антибиотиков обязательно проконсультируйтесь с лечащим врачом.
«Амоксициллин». Обладает свойством подавления инфекции, купирует ее размножение и негативное воздействие на организм. Блокирует выработку пептидогликана.
«Банеоцин». Мазь для лечения стафилококка при поражении кожи. Основана на сочетании двух антибиотиков — бацитрацина и неомицина.
«Ванкомицин». Способствует гибели бактерии, благодаря блокированию компонента, который входит в состав ее клеточной мембраны. Применяется внутривенно.
«Кларитомицин», «Клиндамицин» и «Эритромицин». Блокируют выработку бактериями своих белков, без которых они гибнут.
«Клоксациллин». Блокирует размножение стафилококка, за счет блокирования их мембран, присутствующих при стадии деления их клеток. Обычно назначается в дозе 500 мг/6 часов.
«Мупироцин» – антибактериальная мазь при стафилококковых поражениях кожи. Используется для наружного применения. Основой мази служат три антибиотика – бактробан, бондерм и супироцин.
«Оксациллин». Блокирует деление клеток бактерии, тем самым разрушает их. Способ применения – пероральный, внутривенно и внутримышечно.
«Цефазолин» и «Цефалексин». Блокирует синтез бактерией компонентов, входящие в ее стенки, за счет чего они разрушаются.
«Цефалотин» и «Цефотаксим». Блокируют размножение инфекции, путем нарушения их способности нормального деления. Также разрушают мембраны бактерий.
Лечение стафилококка народными средствами

Медь. Кожные гнойные раны, причиной которых стал золотистый стафилококк, можно обрабатывать медным купоросом, который уничтожает этот вид бактерии. Для профилактики, в быту можно использовать медные предметы кухонной утвари – тазы, кастрюли, кружки и т.д.
Хлорофиллипт. Можно использовать для лечения, как кожных заболеваний, так и заболеваний ЛОР-органов. Для лечения ЛОР-заболеваний, можно использовать спиртовой и масляный растворы. Спиртовым полощут горло или промывают носовые полости, масляным закапывают нос, обрабатывают воспаленные миндалины. Курс лечения 4-10 дней. Маленьким детям вместо полоскания, воспаленные участки смазывают тампоном, смоченным масляным раствором.
Черная смородина. Ягоды черной смородины являются природным антибиотиком, в том числе и против стафилококковой инфекции. Для лечения после каждого приема пищи нужно принимать по стакану ягод смородины. Таким образом, благодаря составу этой ягоды, укрепляется иммунная система, а также купируется инфекция. Фактически, это двойной удар по болезни. Замечено также повышение эффективности при одновременном применение смородины и антибактериальных препаратов.
Лопух и окопник. В пропорции 1:1, сделайте смесь из предварительно высушенных и измельченных частей листьев лопуха и окопника. Полученную смесь нужно залить кипятком, накрыть плотно крышкой и дать настоятся около 20 минут. Принимать средство нужно в теплом виде, 3 раза в день. До полного выздоровления.
Лопух. Отмечается и антибактериальное и заживляющее действие на организм свежих листьев лопуха, которые в лечебных целях промывают, прикладывают к поврежденной воспаленной коже, приматывая его повязкой.
Абрикос. При воспалительных процессах на коже из-за стафилококковой инфекции хорошо зарекомендовала себя мякоть абрикоса, которую нужно прикладывать к очагам воспаления. Для лечения внутренней инфекции нужно кушать пюре из абрикосов 2 раза в день – утром и вечером, натощак.
Яблочный уксус. Для лечения кожных болезней из-за данной бактерии, можно использовать и яблочный уксус. Для этого нужно добавить в ванну, в горячую воду 50 г яблочного уксуса. Принимать такие ванны можно 2-3 раза в день, по 15 минут. Локально, для обработки кожи, можно применять и компресс из смеси яблочного уксуса. Для этого размешайте 2 ст. ложки уксуса в стакане воды.
Профилактика стафилококка
Профилактика стафилококка включает в себя следующие рекомендации:
— Соблюдайте правила личной гигиены – не употребляйте пищу грязными руками, а также неомытые продукты питания;
— Не оставляйте на самотек возможные очаги инфекции – кариес зубов, конъюнктивиты, воспаленные миндалины, аденоиды, фурункулы (чирьи), воспаления в мочеполовой системе и т.д.;
— Делайте в доме влажную уборку не менее 2 раз в неделю, чтобы не допускать в жилом помещении скопления большого количества пыли;
— Чаще проветривайте помещение;
— В сезон респираторных заболеваний, избегайте мест большого скопления людей;
— Старайтесь больше двигаться, занимайтесь спортом;
— Закаляйте свой организм;
— При питании делайте акцент на продукты, богатые на витамины и микроэлементы;
— В жаркую погоду избегайте питания кондитерскими, мясными, молочными и другими изделиями, которые хранятся не в надлежащих условиях;
— При травмировании кожных покровов, обязательно обработайте рану антисептическими средствами, после закройте ее пластырем;
— Старайтесь не посещать салоны красоты, татту-салоны, солярии или стоматологические клиники сомнительного характера, где могут не придерживаться санитарных норм по обработке медицинских инструментов.
Микроорганизм, способствующий развитию различных инфекционных болезней в человеческом организме, называется стафилококк. Этот тип бактерий имеет несколько видов, и только анализ крови на стафилококк позволяет определить роль, которую играет в организме выявленный вид, и назначить соответствующее лечение. Разобраться для чего и как сдать анализ на стафилококк поможет информация, изложенная в этой статье.
Особенности стафилококка
Бактерии стафилококка постоянные спутники человеческой жизнедеятельности, и не все они опасны, как возбудители инфекции. Порядка десяти видов этой шарообразной бактерии могут без вреда для организма человека существовать на его кожных покровах. Всего науке известно около тридцати видов стафилококка, но наиболее опасными считаются стафилококки: эпидермальный, сапрофитный и золотистый.
Их деятельность приводит к нарушению иммунной защиты, и появлению энтеротоксинов, отходов жизнедеятельности этой бактерии.
Сапрофитный стафилококк
Обычно локализируется в мочевыводящих путях. Его жертвами обычно становятся женщины, у мужчин данный вид инфекции менее распространен. При поражении организма сапрофитным стафилококком страдает в первую очередь мочевой пузырь. Катализатором инфекции обычно становится попадание, нормально расположенных на кожном покрове бактерий, в кровь через рану и при ослабленном иммунитете развивается заболевание.
Золотистый стафилококк
Этот вид стафилококка является самым опасным для людей обоих полов и любого возраста. Воздействие на золотистый стафилококк обычными антисептиками не может его ликвидировать, и прижигание пораженных участков спиртом, другими средствами, не может остановить распространение инфекции.
Как и сапрофитный тип стафилококка, золотистый может попадать в кровь через открытые раны, но есть опасность заражения при приеме продуктов и истекшим сроком годности.
Золотистый стафилококк может присутствовать в незначительных нормированных значениях в организме человека, и эта норма может отличаться по возрастным показателям. Так для только что родившегося малыша норма не должна превышать четвертую степень, хотя этот вид стафилококка может вообще отсутствовать в организме детей, но такое явление отмечается не часто.
Важно! Стафилококк передается воздушно-капельным путем и через бытовые контакты.
Попадание патогенного микроорганизма может вызвать множество тяжелейших заболеваний, таких как: тонзиллит, уретрит, мастит, спровоцировать воспаление легких и аппендицит, цистит, дисбактериоз, развитие гнойных осложнений при инфекциях, перитоните, смертельно опасным может оказаться сепсис, наступающий при попадании стафилококка в кровь.
Анализ на стафилококк позволяет предупредить нежелательное развитие заболеваний и во время принять неотложные меры, для сохранения здоровья человека, а иногда и жизни.
Для борьбы со всеми видами стафилококков применяются лекарственные средства – антибиотики. Для каждого вида болезнетворных бактерий определяется свой антибиотик, так как не существует единого средства, позволяющего бороться со всеми видами стафилококка. Анализ на стафилококк позволяет не только определить его вид, но и в условиях медицинской лаборатории определить, какой тип воздействия необходим, для успешной ликвидации этого патогенного микроорганизма. Такой подход ускоряет процесс лечения и исключает ошибки при назначении лекарственных средств.
Заболевания, вызываемые поражением организма стафилококками, могут иметь и другую природу, другой источник заражения. Помимо бактериальных атак, существуют вирусные, а способ лечения при том и другом виде инфекции, будет существенно отличаться. Для этого важно во время провести анализ на стафилококк и отбросить не правильные варианты диагноза. Лечение пациента без предварительного обследование на природу патогенной инфекции, может привести к отрицательным результатам и еще больше ослабить организм человека.
Причины обращения к врачу
При некоторых проявления болезненного характера, стоит немедленно обратиться к врачу. Такими показаниями чаще бывают:
- проявление сыпи на кожном покрове;
- воспаление сальных и потовых желез;
- длительное время наблюдающийся насморк, который не возможно вылечить обычными средствами;
- боли в горле;
- кашель сухого типа и влажного;
- повышение температуры тела, происходящее внезапно.
Для определения патогена стоит провести анализ на стафилококк, что позволит откинуть вероятность развития инфекции именно по причине атаки этих бактерий.
Внимание! Часто стафилококк поражает людей по профессиональному признаку.
Так наиболее подвержены заболеваниям работники медицины, сельского хозяйства и те работники, труд которых может быть связан с частыми мелкими травмами кожного покрова. Велик риск для диабетиков, людей с ВИЧ, онкологических больных.
Как происходит забор материала для анализа на стафилококк
Для получения направления на исследования следует обратиться к лечащему доктору, который определит необходимость прохождения тестов, а так же укажет где можно сдать анализ на стафилококк и как подготовиться к тестированию.
Доктор определяет, какой биологический материал следует задействовать при подозрении на поражение организма стафилококком. Помимо крови это может быть материал из носовой полости, мазок с поверхности горла и прочих слизистых поверхностей. Исследовать возможно материнское молоко, кал и мочу.
Перед проведением анализов на стафилококк необходимо за два месяца прекратить прием любых противовирусных препаратов. Воздействие лекарства может заглушить проявление патогенных микроорганизмов и не позволит определить верную причину заболевания пациента, что отрицательно скажется на выборе методов лечения.
При осуществлении забора материала на анализ со слизистых оболочек пациента рекомендуется больше потреблять воды перед тестированием, зубы, перед сдачей анализов, не чистят. Сдача анализов происходит в утренние часы, и приходить в лабораторию необходимо натощак. До проведения анализов, за 3-4 дня необходимо отказаться от алкоголя и непосредственно в день сдачи анализов от курения.
При заборе мочи следует за два дня, до назначенной даты сдачи анализов, отказаться от приема мочегонных средств. Когда принимается на анализ кал, следует отказаться от приема препаратов слабительного типа.
Расшифровка анализа на стафилококк
Для того, чтобы понять что показывает анализ крови на стафилококк необходимо понимать процесс развития бактерий в целом. В лабораторных условиях создается искусственная среда, в которую помещают микроорганизмы, среда питательная и бактерии в ней начинают увеличивать свою колонию. Процесс обычно наблюдается в течение почти 20 часов, соответственно получить информацию о положительном или отрицательном результате нахождения болезнетворных стафилококков в организме пациента, можно будет только на 4 рабочий день. В некоторых случаях могут назначаться дополнительные виды исследований.
Когда анализы подтверждают наличие патогенных микроорганизмов, это означает наличие инфекционного процесса в организме человека, или пациент может быть переносчиком данного вида стафилококка. Переносчик может и не подозревать о заражении, так как явных болезненных проявлений не наблюдается.








